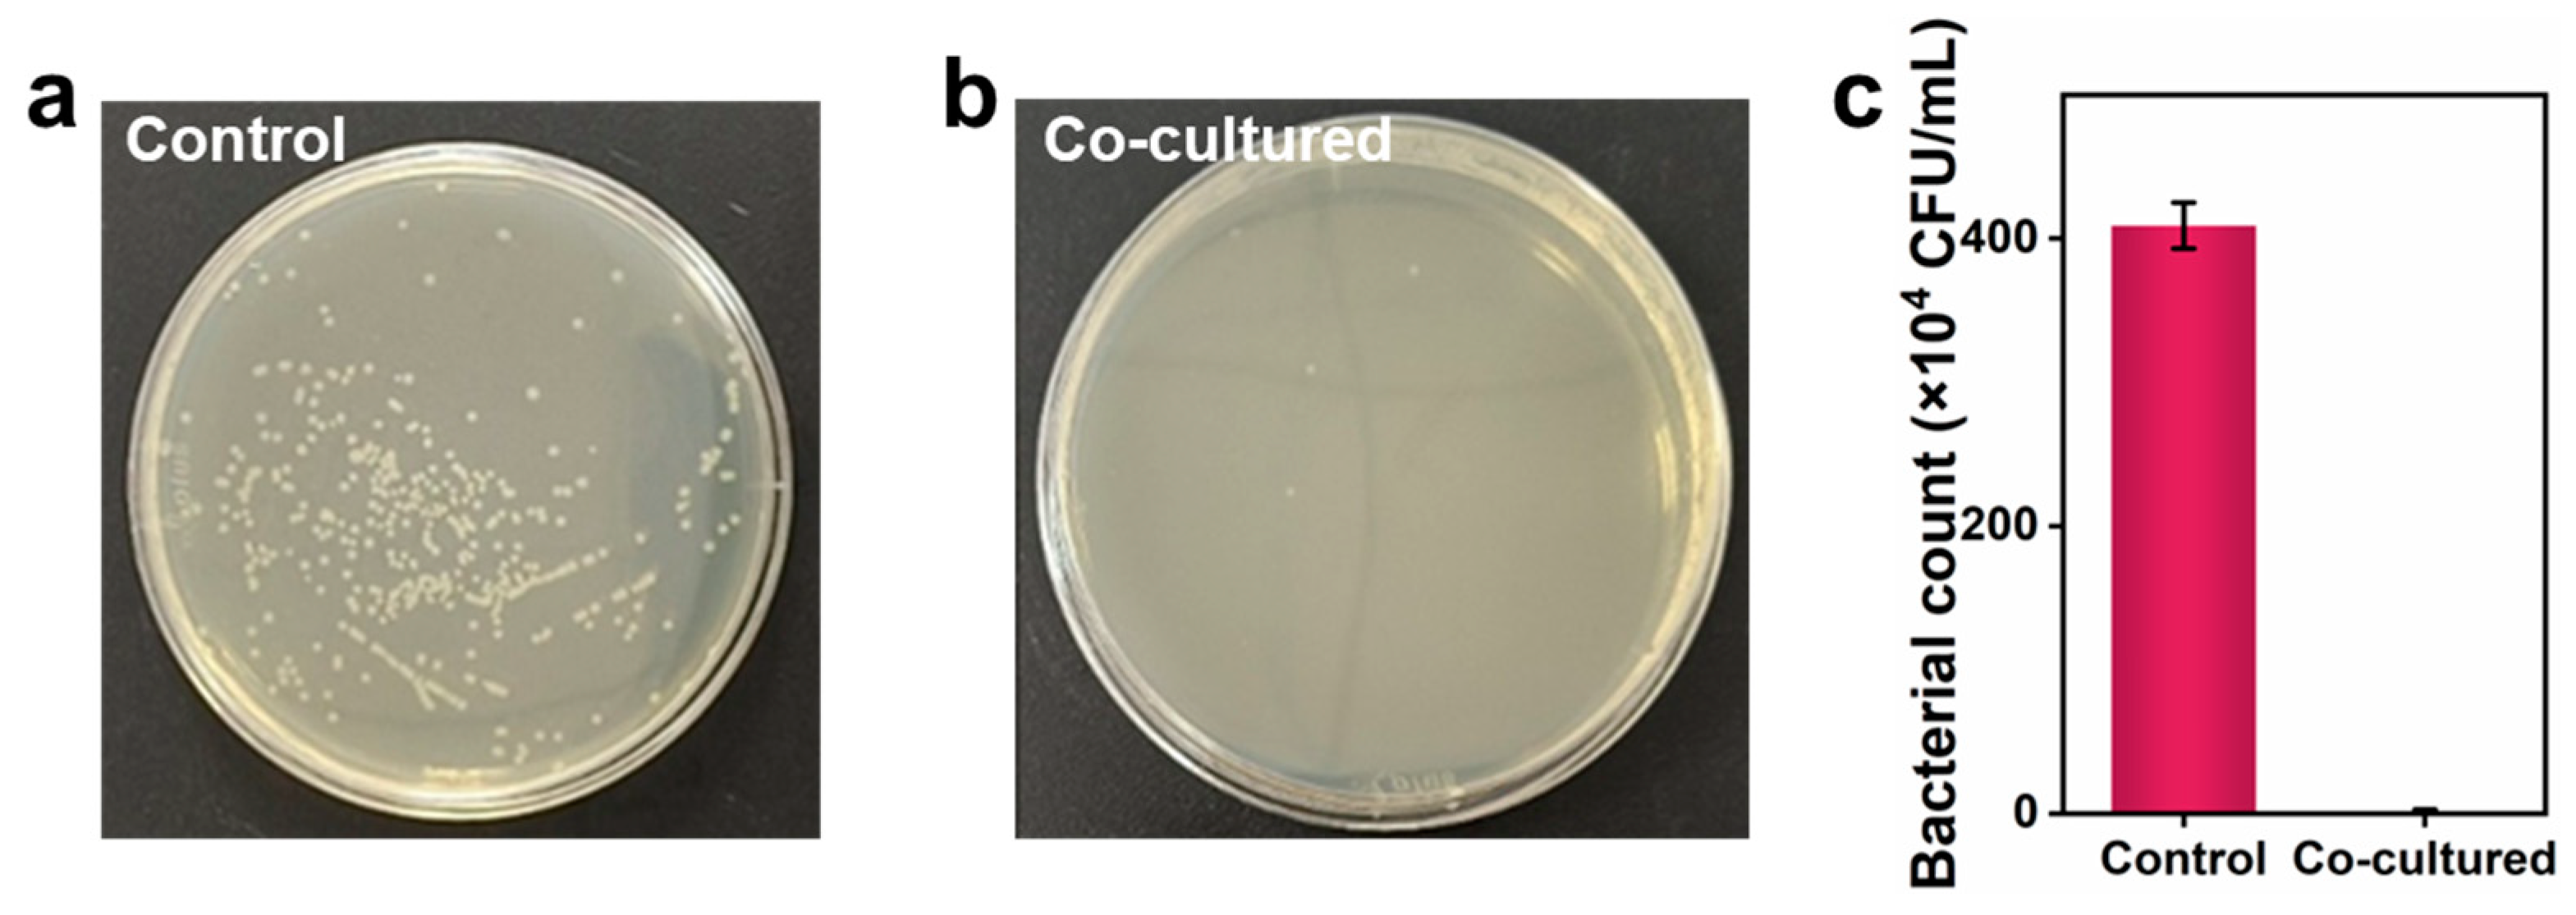
Nanomaterials 15 00515 g004

Sustainable Cellulose Nanofibril−Stabilized Pickering Emulsions for Fresh Egg Preservation
Abstract
1. Introduction
2. Materials and Methods
2.1. Materials
2.2. Preparation of Coating Emulsions and Films
2.3. Characterization
2.4. Measurement of Emulsion Properties
2.5. Mechanical and Water Barrier Properties of the Emulsion-Derived Films
2.6. Antibacterial Performance of the Emulsion-Derived Films
2.7. Wettability of the Coating Emulsion
2.8. Evaluation of Egg Quality During Storage
3. Results
3.1. Characterization of the CNFs
3.2. Optimization of the Weight Ratio of Coconut Oil to CNFs
3.2.1. Stability of the Emulsions
3.2.2. Mechanical and Water Barrier Properties of the Films from Emulsions
3.3. Antibacterial Performance of the Coatings
3.4. Interaction of Coating with Eggshell Surface
3.5. Effects of Coating Emulsion on Egg Quality and Shelf Life
3.5.1. Sensory Evaluation
3.5.2. Weight Loss
3.5.3. Haugh Unit
3.5.4. Albumen pH
3.5.5. Yolk Index
4. Conclusions
Supplementary Materials
Author Contributions
Funding
Data Availability Statement
Conflicts of Interest
References
- FAO. FAO/Foodsecurity Report. Available online: https://media.un.org/unifeed/en/asset/d323/d3239510 (accessed on 24 July 2024).
- Réhault-Godbert, S.; Guyot, N.; Nys, Y. The golden egg: Nutritional value, bioactivities, and emerging benefits for human health. Nutrients 2019, 11, 684. [Google Scholar] [CrossRef] [PubMed]
- Lima, H.; Souza, L. Vitamin A in the diet of laying hens: Enrichment of table eggs to prevent nutritional deficiencies in humans. World’s Poult. Sci. J. 2018, 74, 619–626. [Google Scholar] [CrossRef]
- Wallace, T.C.; Blusztajn, J.K.; Caudill, M.A.; Klatt, K.C.; Natker, E.; Zeisel, S.H.; Zelman, K.M. Choline: The Underconsumed and Underappreciated Essential Nutrient. Nutr. Today 2018, 53, 240–253. [Google Scholar] [CrossRef] [PubMed]
- Sharaf Eddin, A.; Ibrahim, S.A.; Tahergorabi, R. Egg quality and safety with an overview of edible coating application for egg preservation. Food Chem. 2019, 296, 29–39. [Google Scholar] [CrossRef]
- Zhang, Y.; Liu, K.; Zhang, Z.; Tian, S.; Liu, X.; Qi, H.; Dong, D.; Wang, Y.; Liu, M.; Li, X. A severe gastroenteritis outbreak of Salmonella enterica serovar enteritidis linked to contaminated egg fried rice, China, 2021. Front. Microbiol. 2021, 12, 779749. [Google Scholar] [CrossRef]
- Figueiredo, T.C.; Assis, D.C.; Menezes, L.D.; Oliveira, D.D.; Lima, A.L.; Souza, M.R.; Heneine, L.G.; Cançado, S.V. Effects of packaging, mineral oil coating, and storage time on biogenic amine levels and internal quality of eggs. Poult. Sci. 2014, 93, 3171–3178. [Google Scholar] [CrossRef]
- da Silva Pires, P.G.; da Silva Pires, P.D.; Cardinal, K.M.; Bavaresco, C. The use of coatings in eggs: A systematic review. Trends Food Sci. Technol. 2020, 106, 312–321. [Google Scholar] [CrossRef]
- Peerzada Gh, J.; Sinclair, B.J.; Perinbarajan, G.K.; Dutta, R.; Shekhawat, R.; Saikia, N.; Chidambaram, R.; Mossa, A.-T. An overview on smart and active edible coatings: Safety and regulations. Eur. Food Res. Technol. 2023, 249, 1935–1952. [Google Scholar] [CrossRef]
- Raghav, P.K.; Agarwal, N.; Saini, M. Edible coating of fruits and vegetables: A review. Int. J. Sci. Res. Mod. Edu. 2016, 1, 188–204. [Google Scholar] [CrossRef]
- Caner, C.; Yüceer, M. Efficacy of various protein-based coating on enhancing the shelf life of fresh eggs during storage. Poult. Sci. 2015, 94, 1665–1677. [Google Scholar] [CrossRef]
- Pirsa, S.; Aghbolagh Sharifi, K. A review of the applications of bioproteins in the preparation of biodegradable films and polymers. J. Chem. Lett. 2020, 1, 47–58. [Google Scholar] [CrossRef]
- Coltelli, M.-B.; Wild, F.; Bugnicourt, E.; Cinelli, P.; Lindner, M.; Schmid, M.; Weckel, V.; Müller, K.; Rodriguez, P.; Staebler, A.; et al. State of the Art in the Development and Properties of Protein-Based Films and Coatings and Their Applicability to Cellulose Based Products: An Extensive Review. Coatings 2016, 6, 1. [Google Scholar] [CrossRef]
- Nongtaodum, S.; Jangchud, A.; Jangchud, K.; Dhamvithee, P.; No, H.K.; Prinyawiwatkul, W. Oil Coating Affects Internal Quality and Sensory Acceptance of Selected Attributes of Raw Eggs during Storage. J. Food Sci. 2013, 78, S329–S335. [Google Scholar] [CrossRef] [PubMed]
- Caner, C.; Cansiz, O. Effectiveness of chitosan-based coating in improving shelf-life of eggs. J. Sci. Food Agric. 2007, 87, 227–232. [Google Scholar] [CrossRef]
- Xie, B.; Zhang, X.; Luo, X.; Wang, Y.; Li, Y.; Li, B.; Liu, S. Edible coating based on beeswax-in-water Pickering emulsion stabilized by cellulose nanofibrils and carboxymethyl chitosan. Food Chem. 2020, 331, 127108. [Google Scholar] [CrossRef]
- Mouzakitis, C.-K.; Sereti, V.; Matsakidou, A.; Kotsiou, K.; Biliaderis, C.G.; Lazaridou, A. Physicochemical properties of zein-based edible films and coatings for extending wheat bread shelf life. Food Hydrocoll. 2022, 132, 107856. [Google Scholar] [CrossRef]
- Sun, R.; Song, G.; Zhang, H.; Zhang, H.; Chi, Y.; Ma, Y.; Li, H.; Bai, S.; Zhang, X. Effect of basil essential oil and beeswax incorporation on the physical, structural, and antibacterial properties of chitosan emulsion based coating for eggs preservation. LWT 2021, 150, 112020. [Google Scholar] [CrossRef]
- da Silva Pires, P.G.; Bavaresco, C.; da Silva Pires, P.D.; Cardinal, K.M.; Leuven, A.F.R.; Andretta, I. Development of an innovative green coating to reduce egg losses. Clean. Eng. Technol. 2021, 2, 100065. [Google Scholar] [CrossRef]
- Garavand, F.; Nooshkam, M.; Khodaei, D.; Yousefi, S.; Cacciotti, I.; Ghasemlou, M. Recent advances in qualitative and quantitative characterization of nanocellulose-reinforced nanocomposites: A review. Adv. Colloid Interface Sci. 2023, 318, 102961. [Google Scholar] [CrossRef]
- Phanthong, P.; Reubroycharoen, P.; Hao, X.; Xu, G.; Abudula, A.; Guan, G. Nanocellulose: Extraction and application. Carbon Resour. Convers. 2018, 1, 32–43. [Google Scholar] [CrossRef]
- Yin, R.; Yang, S.; Li, Q.; Zhang, S.; Liu, H.; Han, J.; Liu, C.; Shen, C. Flexible conductive Ag nanowire/cellulose nanofibril hybrid nanopaper for strain and temperature sensing applications. Sci. Bull. 2020, 65, 899–908. [Google Scholar] [CrossRef] [PubMed]
- Dickinson, E. Hydrocolloids at interfaces and the influence on the properties of dispersed systems. Food Hydrocoll. 2003, 17, 25–39. [Google Scholar] [CrossRef]
- Deen, A.; Visvanathan, R.; Wickramarachchi, D.; Marikkar, N.; Nammi, S.; Jayawardana, B.C.; Liyanage, R. Chemical composition and health benefits of coconut oil: An overview. J. Sci. Food Agric. 2021, 101, 2182–2193. [Google Scholar] [CrossRef]
- Cho, W.Y.; Ng, J.F.; Yap, W.H.; Goh, B.H. Sophorolipids—Bio-Based Antimicrobial Formulating Agents for Applications in Food and Health. Molecules 2022, 27, 5556. [Google Scholar] [CrossRef]
- Wang, D.; Xiao, H.; Lyu, X.; Chen, H.; Wei, F. Lipid oxidation in food science and nutritional health: A comprehensive review. Oil Crop Sci. 2023, 8, 35–44. [Google Scholar] [CrossRef]
- Arora, J.; Ranjan, A.; Chauhan, A.; Biswas, R.; Rajput, V.D.; Sushkova, S.; Mandzhieva, S.; Minkina, T.; Jindal, T. Surfactant pollution, an emerging threat to ecosystem: Approaches for effective bacterial degradation. J. Appl. Microbiol. 2022, 133, 1229–1244. [Google Scholar] [CrossRef]
- Chen, S.; Yue, N.; Cui, M.; Penkova, A.; Huang, R.; Qi, W.; He, Z.; Su, R. Integrating direct reuse and extraction recovery of TEMPO for production of cellulose nanofibrils. Carbohydr. Polym. 2022, 294, 119803. [Google Scholar] [CrossRef]
- Pan, D.; Li, Y.; Hu, Y.; Li, R.; Gao, X.; Fan, X.; Fang, H.; Du, Q.; Zhou, C. Effect of different concentrations of gellan gum with/without 0.50% basil essential oil on the physicochemical properties of gellan gum-rice bran oil coating emulsions and their application in egg preservation. Food Chem. 2023, 418, 136030. [Google Scholar] [CrossRef]
- GB/T 1040.3-2006; Plastics. Determination of tensile properties. Part 3: Test conditions for films and sheets. General Administration of Quality Supervision, Quarantine of the People’s Republic of China, Standardization Administration of the People’s Pepublic of China: Beijing, China, 2006.
- GB/T 1037-2021; Test method for water vapor transmission of plastic film and sheet—Desiccant method and water method. Standardization Administration of the People’s Pepublic of China, State Administration for Market Regulation: Beijing, China, 2021.
- Deng, Z.; Jung, J.; Simonsen, J.; Zhao, Y. Cellulose nanomaterials emulsion coatings for controlling physiological activity, modifying surface morphology, and enhancing storability of postharvest bananas (Musa acuminate). Food Chem. 2017, 232, 359–368. [Google Scholar] [CrossRef]
- Moats, W. Egg washing—A review. J. Food Prot. 1978, 41, 919–925. [Google Scholar] [CrossRef]
- Wang, L.; Chen, C.; Wang, J.; Gardner, D.J.; Tajvidi, M. Cellulose nanofibrils versus cellulose nanocrystals: Comparison of performance in flexible multilayer films for packaging applications. Food Packag. Shelf Life 2020, 23, 100464. [Google Scholar] [CrossRef]
- Cano-Sarmiento, C.; Téllez-Medina, D.I.; Viveros-Contreras, R.; Cornejo-Mazón, M.; Figueroa-Hernández, C.Y.; García-Armenta, E.; Alamilla-Beltrán, L.; García, H.S.; Gutiérrez-López, G.F. Zeta Potential of Food Matrices. Food Eng. Rev. 2018, 10, 113–138. [Google Scholar] [CrossRef]
- Goodarzi, F.; Zendehboudi, S. A comprehensive review on emulsions and emulsion stability in chemical and energy industries. Can. J. Chem. Eng. 2019, 97, 281–309. [Google Scholar] [CrossRef]
- He, Y.; Wang, C.; Liu, Y.; Chen, J.; Wei, Y.; Chen, G. Pickering emulsions stabilized by cellulose nanofibers with tunable surface properties for thermal energy storage. Int. J. Biol. Macromol. 2024, 280, 136013. [Google Scholar] [CrossRef]
- Bhasney, S.M.; Patwa, R.; Kumar, A.; Katiyar, V. Plasticizing effect of coconut oil on morphological, mechanical, thermal, rheological, barrier, and optical properties of poly(lactic acid): A promising candidate for food packaging. J. Appl. Polym. Sci. 2017, 134, 45390. [Google Scholar] [CrossRef]
- Fan, Z.; Hao, Y.; Wang, Y.; Hu, X.; Li, T. Characterisation of hyaluronic acid-curcumin-cellulose nanofibre composite film and application in egg preservation. Int. J. Food Sci. Technol. 2023, 58, 6263–6271. [Google Scholar] [CrossRef]
- Irfan, M.; Gading, B.M.W.T.; Sukoco, H.; Mukhlisah, A.N.; Maruddin, F.; Prahesti, K.I. Weight loss and yolk index of commercial chicken eggs as affected by sappan wood extract (Caesalpinia sappan L.) and storage time. AIP Conf. Proc. 2023, 2628, 050024. [Google Scholar] [CrossRef]
- Wang, J.; Gardner, D.J.; Stark, N.M.; Bousfield, D.W.; Tajvidi, M.; Cai, Z. Moisture and oxygen barrier properties of cellulose nanomaterial-based films. ACS Sustain. Chem. Eng. 2018, 6, 49–70. [Google Scholar] [CrossRef]
- Zinke, A.; Pottackal, N.; Zahin, F.; Nur, M.I.; Ahmed, F.; Ji, Y.; Mohammed, Z.; Meyer, M.D.; Miller, C.; Bennett, M.R.; et al. Preserving Fresh Eggs via Egg-Derived Bionanocomposite Coating. Adv. Funct. Mater. 2024, 34, 2310091. [Google Scholar] [CrossRef]
- Fernández-Saiz, P.; Lagaron, J.M. Chitosan for Film and Coating Applications. In Biopolymers—New Materials for Sustainable Films and Coatings; Wiley: Hoboken, NJ, USA, 2011; pp. 87–105. [Google Scholar] [CrossRef]
- Galus, S.; Kadzińska, J. Moisture Sensitivity, Optical, Mechanical and Structural Properties of Whey Protein-Based Edible Films Incorporated with Rapeseed Oil. Food Technol. Biotechnol. 2016, 54, 78–89. [Google Scholar] [CrossRef]
- Casariego, A.; Souza, B.W.S.; Vicente, A.A.; Teixeira, J.A.; Cruz, L.; Díaz, R. Chitosan coating surface properties as affected by plasticizer, surfactant and polymer concentrations in relation to the surface properties of tomato and carrot. Food Hydrocoll. 2008, 22, 1452–1459. [Google Scholar] [CrossRef]
- Yuceer, M.; Caner, C. Antimicrobial lysozyme–chitosan coatings affect functional properties and shelf life of chicken eggs during storage. J. Sci. Food Agric. 2014, 94, 153–162. [Google Scholar] [CrossRef] [PubMed]
- Keener, K.M.; Anderson, K.E.; Curtis, P.A.; Foegeding, J.B. Determination of Cooling Rates and Carbon Dioxide Uptake in Commercially Processed Shell Eggs Using Cryogenic Carbon Dioxide Gas12. Poult. Sci. 2004, 83, 89–94. [Google Scholar] [CrossRef] [PubMed]
- Xu, L.; Zhang, H.; Lv, X.; Chi, Y.; Wu, Y.; Shao, H. Internal quality of coated eggs with soy protein isolate and montmorillonite: Effects of storage conditions. Int. J. Food Prop. 2016, 20, 1921–1934. [Google Scholar] [CrossRef]

| Reagent | Specification | Manufacturer |
|---|---|---|
| 2,2,6,6-tetramethylpiperidine-1-oxyl radical (TEMPO) | ≥95%, GC | Aladdin, Shanghai, China |
| Sodium bromide (NaBr) | ≥99%, AR | Aladdin, Shanghai, China |
| Sodium hydroxide (NaOH) | ≥96%, AR | Aladdin, Shanghai, China |
| Sodium Hypochlorite (NaClO) | Effective chlorine ≥5.0% | Aladdin, Shanghai, China |
| Glycerol | ≥99%, GC | Aladdin, Shanghai, China |
| Phosphate buffer saline buffer solution (PBS) | pH 6.8 | Aladdin, Shanghai, China |
| Food-grade coconut oil (CO) | 95% | Tianjin Hope Technology Co., Ltd., Tianjin, China |
| Sophorolipids | BR | NJDULY, Nanjing, China |
| Cinnamaldehyde | 98% | Tianjin Hope Technology Co., Ltd., Tianjin, China |
| Nutrient agar | BR | Beijing Aobostar Biotechnology, Beijing, China |
| CO/CNFs | Mass of CO (g) | Mass of CNFs (g, Dry Weight) | Mass of Glycerol (g) | Mass of Cinnamaldehyde (g) | Mass of Sophorolipids (g) |
|---|---|---|---|---|---|
| 0.5:1 | 0.5 | 1 | 0.45 | 0.1 | 0.6 |
| 1:1 | 1 | 1 | 0.6 | 0.1 | 0.6 |
| 2:1 | 2 | 1 | 0.9 | 0.1 | 0.6 |
| 3:1 | 3 | 1 | 1.2 | 0.1 | 0.6 |
| 4:1 | 4 | 1 | 1.5 | 0.1 | 0.6 |
Disclaimer/Publisher’s Note: The statements, opinions and data contained in all publications are solely those of the individual author(s) and contributor(s) and not of MDPI and/or the editor(s). MDPI and/or the editor(s) disclaim responsibility for any injury to people or property resulting from any ideas, methods, instructions or products referred to in the content. |
© 2025 by the authors. Licensee MDPI, Basel, Switzerland. This article is an open access article distributed under the terms and conditions of the Creative Commons Attribution (CC BY) license (https://creativecommons.org/licenses/by/4.0/).
Share and Cite
Li, H.; Zhang, L.; Cui, M.; Huang, R.; Su, R. Sustainable Cellulose Nanofibril−Stabilized Pickering Emulsions for Fresh Egg Preservation. Nanomaterials 2025, 15, 515. https://doi.org/10.3390/nano15070515
Li H, Zhang L, Cui M, Huang R, Su R. Sustainable Cellulose Nanofibril−Stabilized Pickering Emulsions for Fresh Egg Preservation. Nanomaterials. 2025; 15(7):515. https://doi.org/10.3390/nano15070515
Chicago/Turabian StyleLi, Hao, Lei Zhang, Mei Cui, Renliang Huang, and Rongxin Su. 2025. "Sustainable Cellulose Nanofibril−Stabilized Pickering Emulsions for Fresh Egg Preservation" Nanomaterials 15, no. 7: 515. https://doi.org/10.3390/nano15070515
APA StyleLi, H., Zhang, L., Cui, M., Huang, R., & Su, R. (2025). Sustainable Cellulose Nanofibril−Stabilized Pickering Emulsions for Fresh Egg Preservation. Nanomaterials, 15(7), 515. https://doi.org/10.3390/nano15070515

